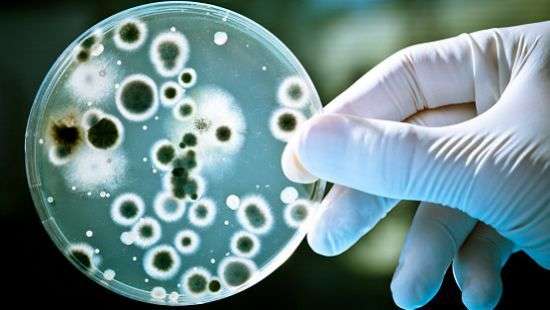
Специалисты придумали, как убить все бактерии

Рубрики
МЕНЮ
Специалисты придумали, как убить все бактерии
Уничтожить все бактерии поможет серебро под электричеством

Виталий Войчук
Ученые изобрели способ полной стерилизации поверхностей от бактерий. Использование посеребренных пластиковых поверхностей совместно с небольшим зарядом электричества приводит к уничтожению всех патогенов.
На сегодняшний день в медицине часто используют серебро и высокие заряды электричества для стерилизации поверхностей. Однако высокая концентрация серебра, как и сильное электрическое поле, могут навредить здоровью пациента, из-за чего эта методика лимитирована.
Исследователи Каролинского института в Швеции нашли способ комбинировать эти две методики для стерилизации пластиковых поверхностей, которые занимают большую часть больничного пространства. Как показали эксперименты, использование слабых зарядов электричества никак не повлияло на популяцию золотистого стафилококка. Нанесение наночастиц серебра на поверхность приостановило рост популяции, но не дало долгосрочного эффекта. При комбинации серебра и электрического разряда в малых концентрациях бактерия была полностью уничтожена.
Технологию пока не тестировали в больницах, но ученые возлагают на нее большие надежды.
Фото: из открытых источников
Читайте Comments.ua в Google News
Новости партнеров


